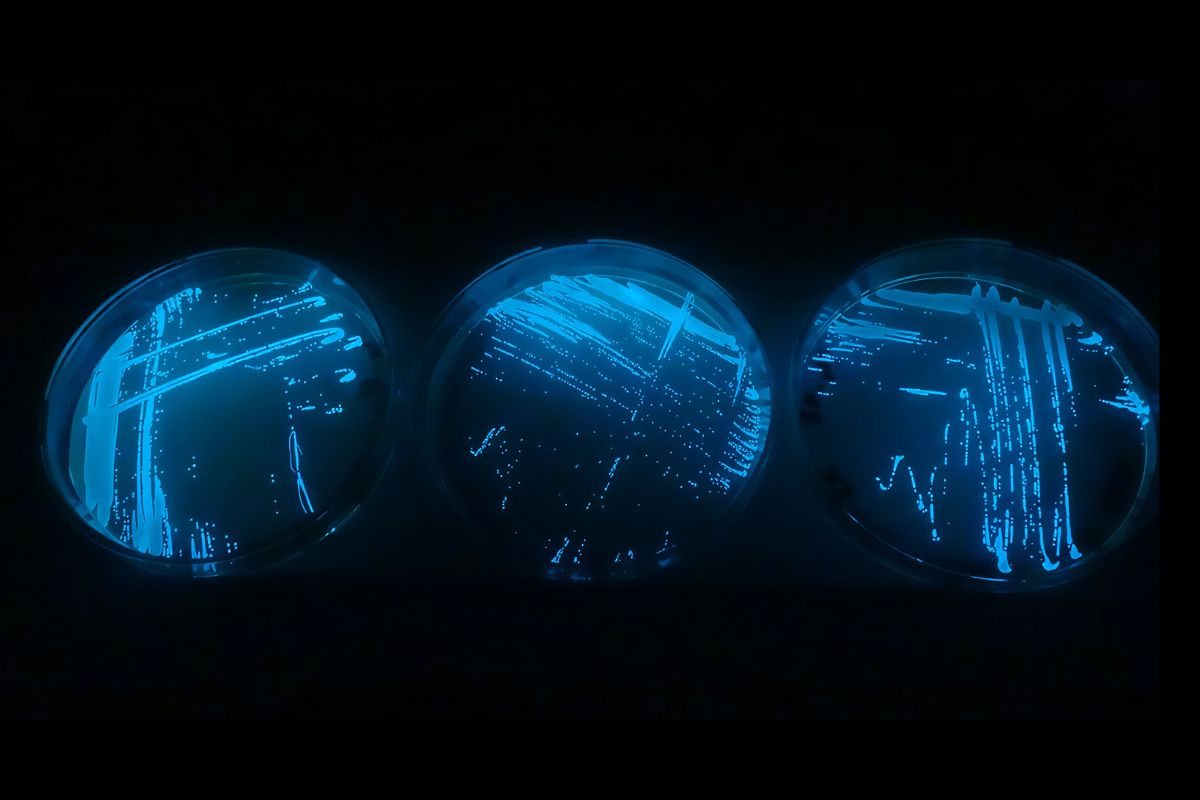

LA BIOLUMINESCENCE
Au cœur du vivant
une lumière qui décode les mystères des profondeurs
Au-delà de l’émerveillement qu’elle suscite, la bioluminescence éclaire aussi les profondeurs marines et les mystères qu’elles renferment. Elle interroge les mécanismes biologiques, chimiques et physiques à l’œuvre dans les abysses, révélant les adaptations extraordinaires du vivant. Cette lumière naturelle, issue de processus moléculaires uniques, devient un outil précieux pour explorer, comprendre, et préserver les écosystèmes marins.
Exploration marine
Nous avons découvert que des bactéries bioluminescentes interfèrent avec les données enregistrées par ANTARÈS, un télescope sous-marin situé à 2400 mètres de profondeur au large de La Seyne-sur-Mer. Cet instrument scientifique est chargé de détecter les neutrinos, particules cosmiques de haute énergie.
Face à ce phénomène, notre équipe étudie désormais ces bactéries bioluminescentes avec une attention particulière.
Pour mener cette étude, nous avons isolé et identifié une bactérie prélevée sur le site d’immersion du télescope. En laboratoire, nous utilisons diverses méthodes d’analyse (mesures de lumière, dégradation de la matière, biologie moléculaire) afin de comprendre :
- le rôle précis de la bioluminescence
- les facteurs environnementaux qui influencent l’émission lumineuse.
équilibres écosystémiques
Dans l’océan, la pompe biologique du carbone est le processus essentiel qui régule la concentration atmosphérique de dioxyde de carbone (CO2). En surface, les organismes photosynthétiques, capables de produire de l’oxygène grâce à l’énergie lumineuse, fixent le carbone avant de le transférer jusqu’aux sédiments des fonds marins.
Les microorganismes jouent un rôle crucial dans ce cycle, étant reconnus comme les principaux agents de minéralisation de ce transfert dans la colonne d’eau. Ils transforment efficacement la matière organique en matière minérale, complétant ainsi ce processus écologique fondamental.
Quand la lumière change tout
Auparavant, les scientifiques pensaient que les petites particules qui tombent vers les fonds marins étaient mangées par le zooplancton uniquement lors de rencontres dues au hasard (voir la figure centrale, partie a). Une fascinante découverte bouleverse cette vision : des bactéries lumineuses s’accrochent à ces particules !
Cette lumière naturelle agit comme un véritable phare sous-marin, attirant les organismes marins plus gros qui viennent alors manger ces particules brillantes. En somme, dans l’obscurité des océans, les particules qui brillent ont beaucoup plus de chances d’être repérées et consommées que celles qui restent invisibles.
Quels impacts sur le stockage du carbone dans l’océan ?
Cette attraction lumineuse des particules pourrait avoir deux effets opposés :
- D’un côté, quand les organismes marins dégradent ces particules brillantes, ils les fragmentent en morceaux plus petits qui descendent plus lentement vers le fond, ralentissant ainsi le stockage du carbone.
- De l’autre côté, ces mêmes organismes, après avoir mangé plusieurs petites particules, produisent des déjections qui coulent plus rapidement, accélérant alors le stockage du carbone.
Les chercheurs travaillent encore à mesurer précisément ces phénomènes pour comprendre leur véritable impact sur notre climat.

technologies bio-inspirées
BATHY BOT / BATHY REEF est un projet innovant intégré à l’infrastructure de recherche EMSO-France et déployé sur le site du Laboratoire Sous-marin Provence Méditerranée (LSPM).
Notre mission principale ? Étudier comment le réchauffement climatique affecte les océans européens. Nous nous intéressons également de près aux fascinants organismes bioluminescents et à leur relation avec les phénomènes physiques des grands fonds marins.
Grâce à cette technologie de pointe, les mystères des abysses deviennent plus accessibles que jamais.
BATHY REEF : un habitat innovant pour la vie abyssale
BATHY REEF est un habitat artificiel conçu pour les grands fonds marins qui attire et révèle les créatures des profondeurs, qu’elles émettent de la lumière ou non.
Notre défi de conception était double :
- Créer une structure à la fois légère et ultra-résistante à la pression des abysses
- Offrir un environnement accueillant pour favoriser l’installation des organismes marins
Inspiré par la nature elle-même, BATHY REEF reproduit l’ingénieuse structure vasculaire des ascidies (animaux marins filtreurs). Cette biomimétique nous permet d’obtenir un résultat remarquable : une architecture délicate mais extrêmement solide, offrant une vaste surface colonisable avec un minimum de matériaux.
Grâce à BATHY REEF, nous étudions comment ces mystérieux habitants des profondeurs colonisent de nouveaux territoires et comment la structure de leur habitat influence leur comportement.


BATHY BOT : explorateur high-tech des fonds marins
BATHY BOT est un petit robot sous-marin semi-autonome qui nous sert d’yeux et d’oreilles dans les profondeurs océaniques. Contrôlable à distance via Internet, ce détective des abysses collecte des données essentielles sur son environnement :
- Température de l’eau
- Niveaux d’oxygène et de CO₂
- Salinité
- Turbidité (clarté de l’eau)
- Activité lumineuse des organismes
Équipé d’une caméra et d’un détecteur de photons ultra-sensible, BATHY BOT capture les moindres étincelles de vie bioluminescente.
BATHY REEF sert également de plateforme surélevée pour notre robot. Cet ingénieux système permet à BATHY BOT de se déplacer sans perturber les sédiments du fond marin, garantissant ainsi des observations claires et l’accès à des espèces qui resteraient autrement invisibles.
Envie d’intégrer la magie de la bioluminescence à vos produits ou événements ?
Ou de collaborer avec nous pour faire avancer les connaissances dans ce domaine fascinant ?
Laissez-nous simplement vos coordonnées et un petit mot, et nous vous contacterons dans les meilleurs délais.